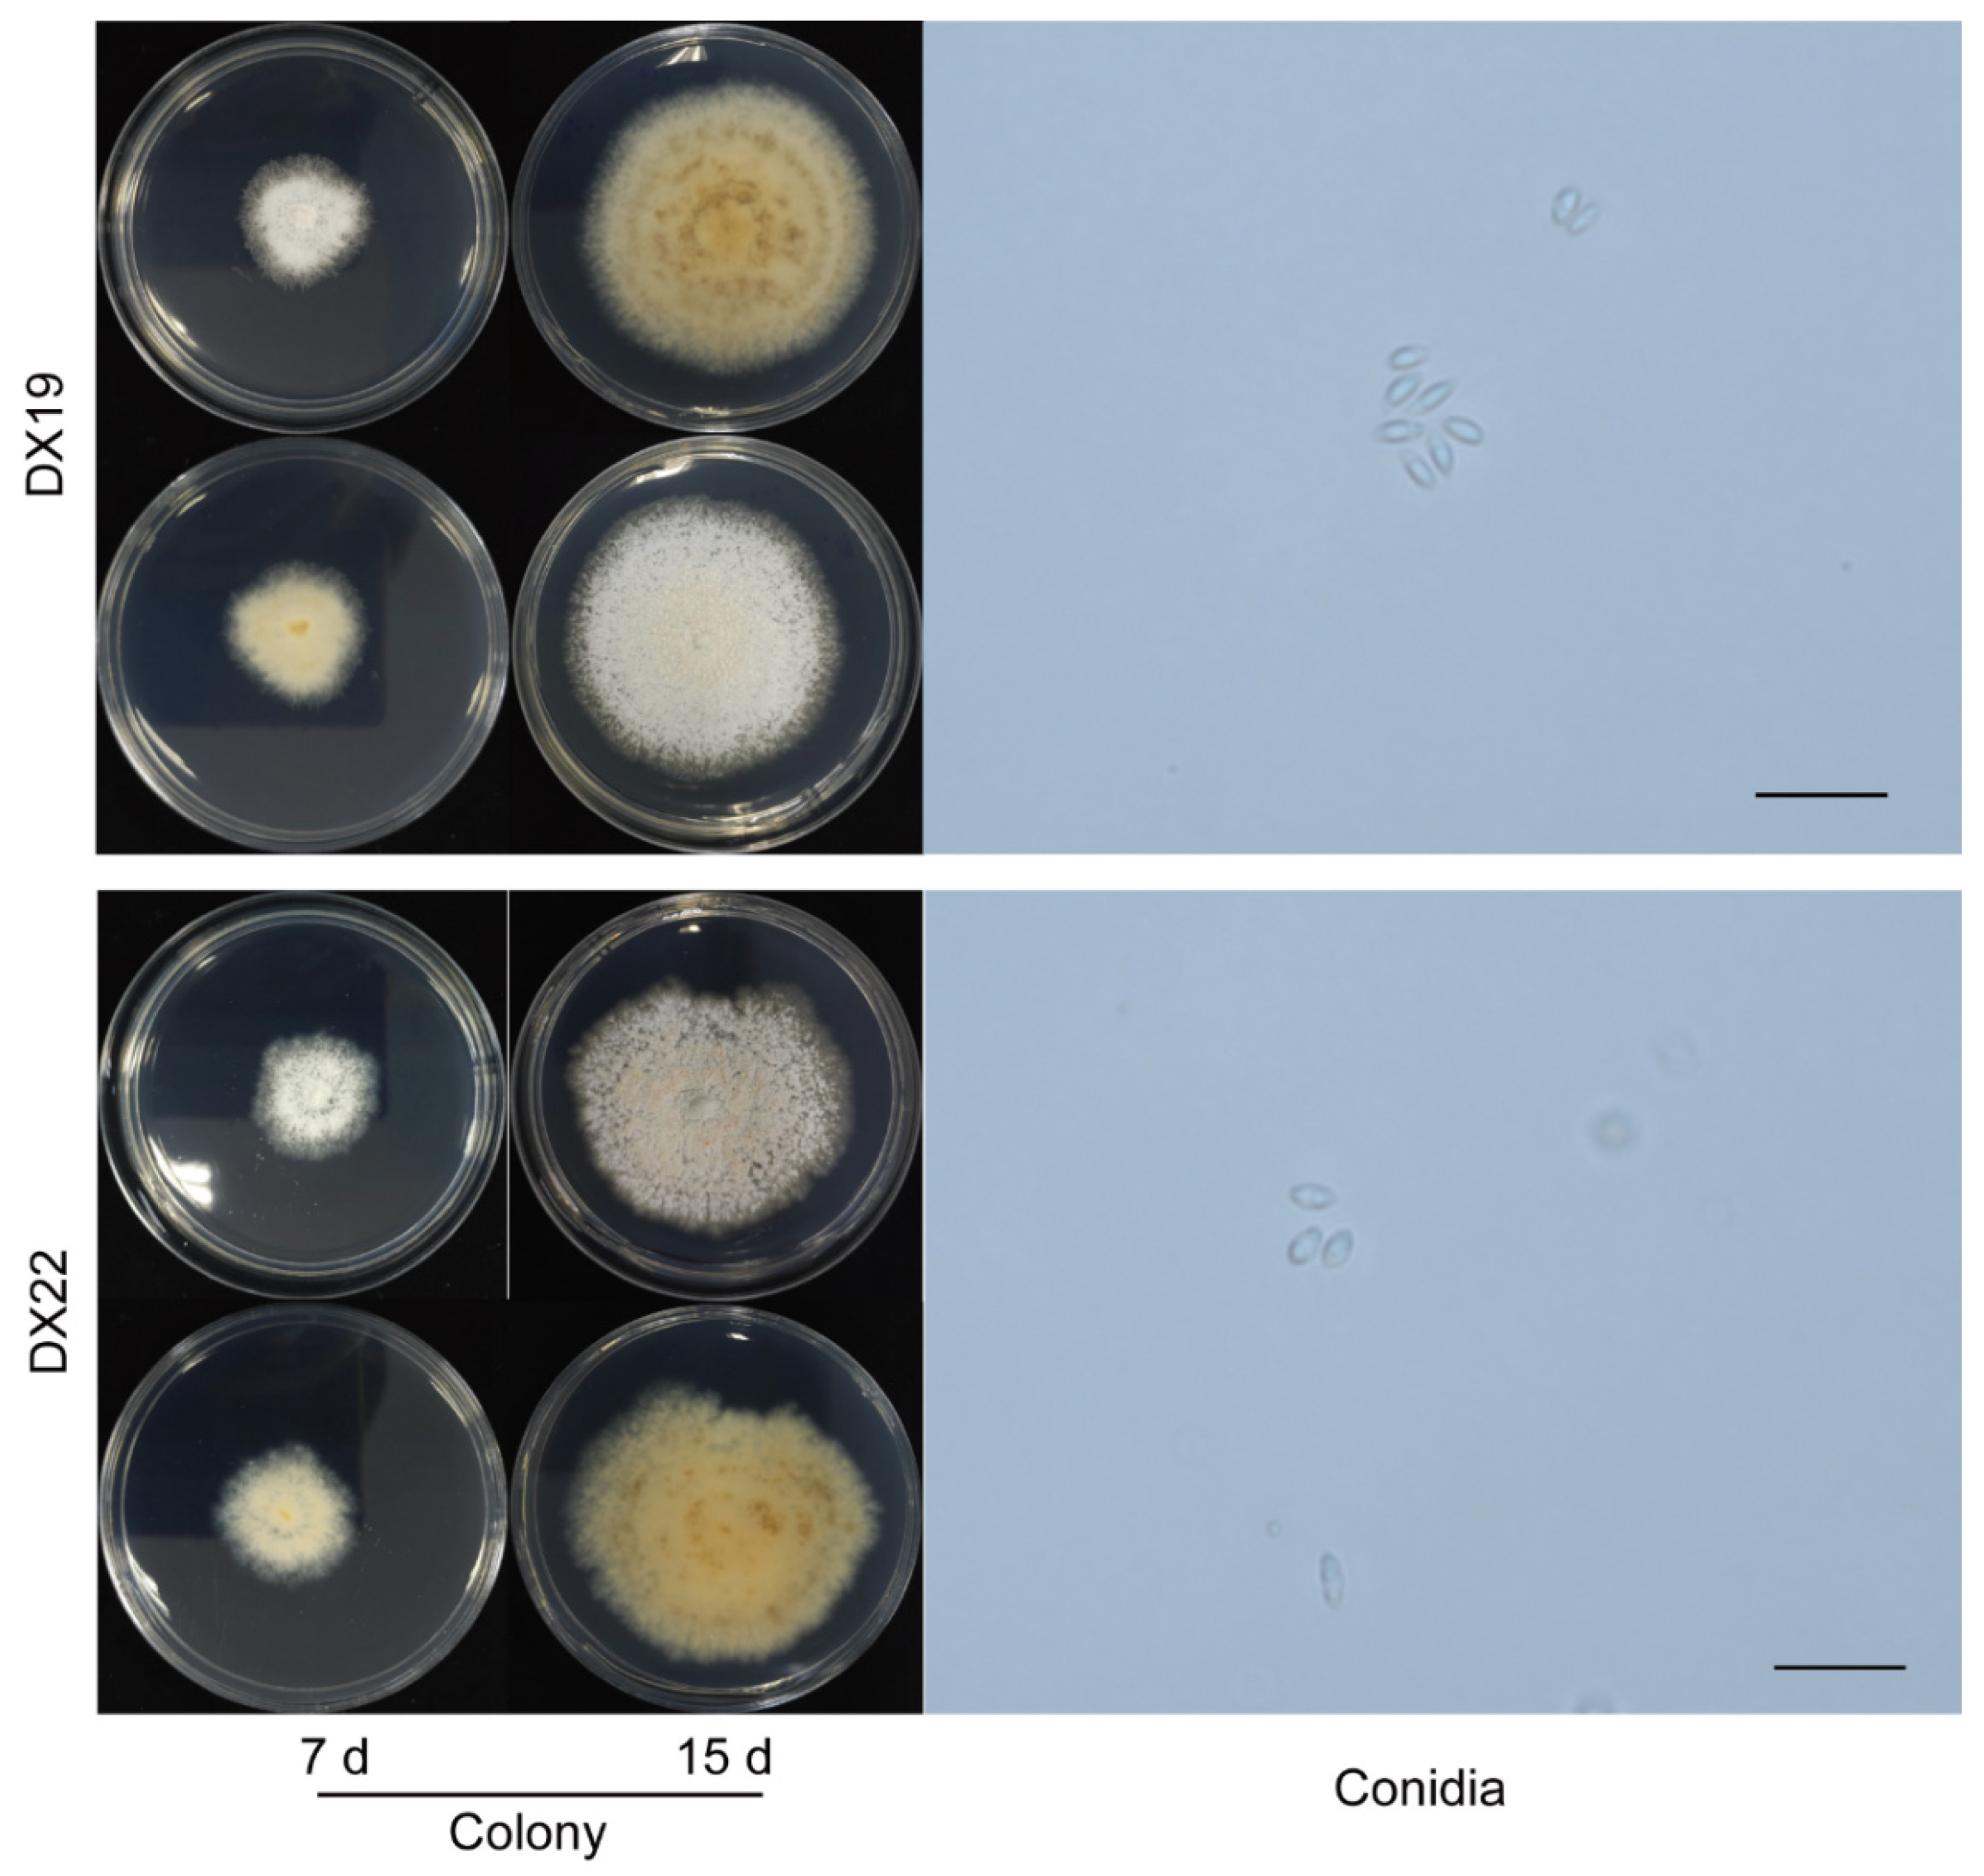
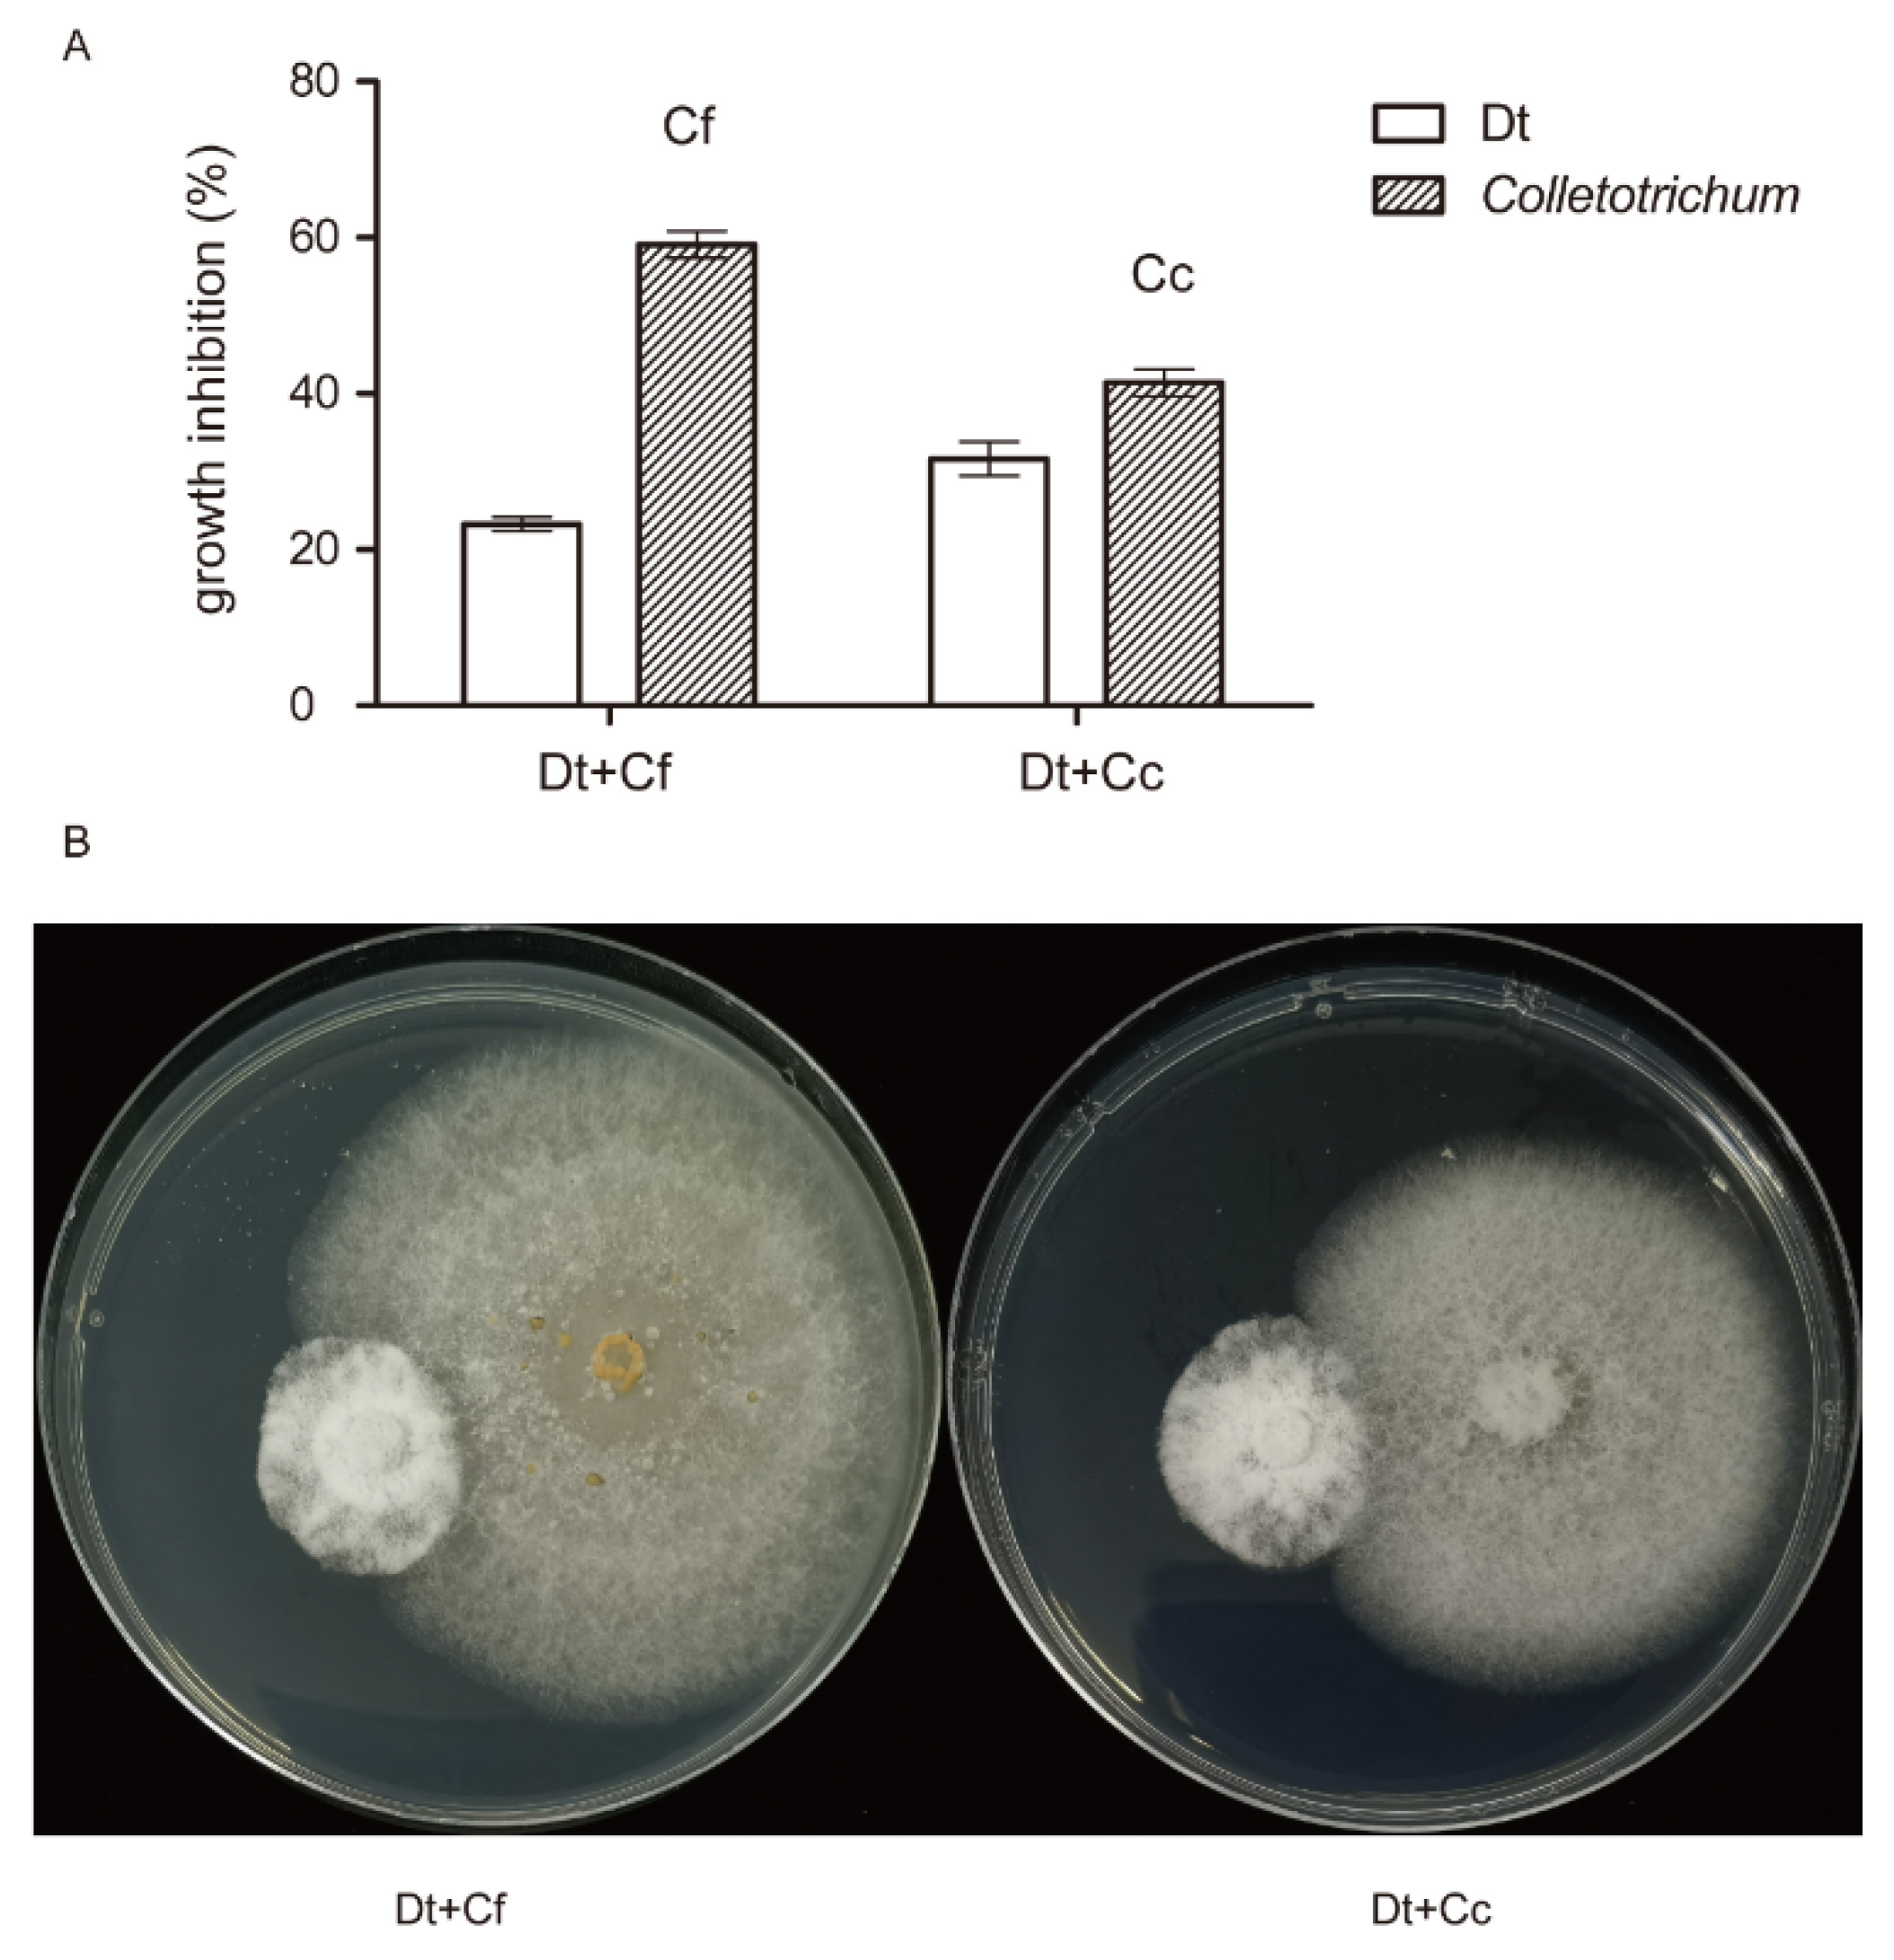

1. Introduction
Tea is a beverage that is consumed worldwide. The productions of tea as cultivation, process, package and exportation are distributed in Asia, Africa, South America and Oceania. Tea industry is a high-output and characteristic agriculture industry in China. However, the yield and quality of tea are highly affected by fungal diseases. Identifying, authenticating and classifying the major tea disease pathogenic microorganisms can help increase efficiency of tea disease control and protect tea production. As the severe and widespread disease of tea plant in China, anthracnose has adverse effects on tea output. Anthracnose occurs mainly in warm moist area, the most serious period is from April to June depending on climatic conditions and regional distribution [
1]. An outbreak of anthracnose in Xinchang of Zhejiang province affected production of main cultivar
Longjing43 (LJ43) and lead to productivity loses of 10–20% [
2]. Anthracnose of tea plants presents various phenotypes due to the wide geographical distribution and different disease courses. Moreover, tea leaf blight, gray blight, anthracnose and other diseases are easily confused.
To date, identification and classification of pathogens causing anthracnose of tea plants in China remain controversial. Over the past several decades, the pathogen causing anthracnose was recognized as
Gloeosporium theae-sinensis [
3]. Nevertheless, the taxonomy of
G. theae-sinensis is ambiguous. Yamamoto proposed that
G. theae-sinensis was an invalid recombination of
C. theae-sinensis which should belong to the
Colletotrichum genus [
4]. However, Moriwaki et al. considered
G. theae-sinensis to be named as
Discula theae-sinensis (Dt) which can be classified into
Diaporthales in terms of morphological and molecular characterization [
5].
The
Diaporthales is an order in the subclass
Sordariomycetes, which can cause anthracnose on various crops and trees [
6,
7,
8]. Based on morphological characteristics and molecular data, the classification of
Diaporthales becomes more distinct, with up to 31 families [
9,
10,
11].
Diaporthales also widely exist in tea plants as pathogens or endophytes. Xie et al. summarized many studies about endophytes in tea plant and listed 3 families of
Diaporthales reported in tea plants as endophytes,
Diaporthaceae, Melanconiellaceae and
Valsaceae [
12]. Cao et al investigated
Diaporthe (
Diaporthecae,
Diaporthale) species associated with symptomatic and asymptomatic tissues of
Camellia and identified four novel species, three known species and two complex species from diseased and healthy tissues of tea plants from several provinces in China [
13]. Dt is common in Japanese tea cultivation, which causes anthracnose of tea plants and enters young tea leaves only through the trichomes [
14,
15]. However, its distribution in China and pathogenicity remain unclear.
In addition to Dt,
Colletotrichum is considered as another major cause of anthracnose in tea plants in China, and is a large genus of Ascomycete fungi belonging to
Melanconiales [
16]. Severe damage caused by
Colletotrichum species can lead to defoliation [
17]. Through sampling in multiple regions, 17 species and 1 indistinguishable strain of
Colletotrichum have been reported to infect tea plants in China [
18,
19]. Among them,
C. camelliae (Cc) and
C. fructicola (Cf) are deemed as dominant species of tea anthracnose disease based on geographic distribution and strain quantity [
18,
20]. Cc probably hosts specific taxa that occur on
Camellia, and Cf have a more diverse host range [
18]. In terms of pathogenicity, Cc is more virulent than Cf on tea plants, which may be caused by secondary metabolites, such as catechins and caffeine [
21]. However, Cc and some
Colletotrichum species are also supposed to be pathogens of tea leaf blight [
22,
23]. Therefore, it is worth defining the major cause of tea plant anthracnose in China.
To clarify the main cause of anthracnose in tea plants in China, we isolated pathogens and collected anthracnose diseased tea leaves for the second year. We chose the different types of diseased tea leaves based on field phenotypes and combined multilocus phylogeny and morphological characteristics to recognize the species of all isolates. A total of 133 isolates were obtained from tea plants over two years, of which 88 were identified as Diaporthales and 45 were Colletotrichum. Dt and Cf were common in Diaporthales and Colletotrichum, respectively. Furthermore, pathogenicity tests were performed on representative Dt isolates and co-inoculation with Dt and Colletotrichum to explore the major cause of tea plant anthracnose in China.
2. Results
2.1. Phenotypic Characterization of Collected Tea Leaves
We collected diseased tea leaves with visible anthracnose symptoms for two consecutive years. Based on phenotypic differences in details, the symptoms of disease samples can be classified into three types. The first pattern (P1) was white disease spots accompanied by black tiny particles on the surface and only existed on one side of the blade. The scabs of second pattern (P2) were tawny with searing on the side of leaves. In the third pattern (P3), lesions were distributed on the distichous sides at the tip of the blade. The similarity of these three groups was watery lesions closed to demarcation between disease and health parts, which appeared translucent to face light, and no ring spots (
Figure 1A).
Based on microscopic examination, the forms of the collected acervuli from diseased tea leaves could be divided into two kinds (
Figure 1B). The first kind of acervuli (A1) was suborbicular and flat, which was the main type among diseased leaves. The second kind of acervuli (A2) was irregular in shape with split at the center. The A2 type only appeared once during procedures of sample collection in this study. In addition, the dominant spores on the scab were divided into 2 types (
Figure 1C). One type was fusiform to obovoid, tapered at the base or both ends (S1), and the other type was cylindrical with obtuse ends (S2). According to their morphological characteristics, we preliminarily considered that S1 was
Diaporthales and S2 was
Colletotrichum. Further studies showed that all isolates collected from type A2 diseased tea leaves were identified as Cf.
2.2. Identification and Characterization of Diaporthales
In our study, we collected 88 isolates of
Diaporthales. Phylogenetic trees (
Figure 2) were constructed using the combined ITS, LSU, EF1 and RPB2 gene data that encompassed 94
Diaporthales strains, including
Lopadostoma polynesium (LAG) as the outgroup. The combined gene alignment, including gaps, comprised 2316 characters and 631, 518, 274 and 893 bases had alignment gaps in ITS, LSU, EF1 and RPB2. The isolates belonged to 6 clades, containing 3 known species, Dt (number of strains: 66),
Diaporthe ueckerae (1),
D. lithocarpus (1), and 3 indistinguishable species described as
Diaporthales spp. 1 (D1), D2 and D3, which contained 2, 16, 2 strains, respectively. The phylogenetic tree had Bayesian posterior probability values ≥ 0.95. Dt was the most common species, which were divided into 3 subclades according to phylogenetic analysis. Of our isolates of
Diaporthales, 80 isolates separated from foliar surface and 8 isolates were endophyte. Dt was the most common species and occurred in pathogens and endophytes.
The growth rate of representative isolates was shown in
Figure 3. The growth rate of DX89 was the highest and significantly higher than that of DX85. The isolates from DT, D1 and D2 grew slowly and have no significant difference between individual isolates. This result showed that D3, DX88 and DX87 grew quite faster than other species. Morphological characteristics and conidial data were obtained from isolates cultured on PDA plates (
Figure 4,
Figure 5 and
Figure 6).
Colony of Dt had discrepant details in 3 different clusters (
Figure 4), growth rate of 2.91 mm per day, with low, dense, fluffy white aerial mycelia, in reverse, some gray-white with brown patches (DX7), and some a uniform gray-white (DX44). The α-conidia were hyaline, fusiform to obovoid, and tapered at the ends. The size of DX7 was 5.6-8.9 × 2.8-4.6 µm, average (av) ± SEM = 7.4 ± 0.1 × 3.4 ± 0.1 µm, n = 30. The size of DX14 was 4.8-9.9 × 2.4-4.3 µm, av ± SEM = 7.1 ± 0.2 × 3.1 ± 0.1 µm, n = 30. The size of DX44 was 6.4-10.3 × 2.6-4.1 µm, av ± SEM = 8.1 ± 0.2 × 3.5 ± 0.1 µm, n = 30.
D1 (DX19) had growth rate of 4.32 mm per day. As shown in
Figure 5. The outline and color of the colony were similar to those of
Discula theae-sinensis, with low, flat, dense aerial mycelia, and roundish edge within 7 days. At 15 days, pale white, aerial mycelium near centre dense cottony, tufted, in reverse with concentric rings of brown pigment. The conidia were aseptate, hyaline, smooth, guttulate, fusoid, tapering towards both ends, measuring 5.4-8.3 × 2.3-3.8 µm, av ± SEM = 6.4 ± 0.1 × 2.9 ± 0.1 µm, n = 30. D2 (DX22) had growth rate of 2.41 mm per day. The colony exhibited white, dense aerial mycelia in the center and low, sparse mycelia on the edge, with light brown coloring on the reverse side; pinkish pigments near center, feathery margins with time going on. The α-conidia were hyaline, guttulate, fusiform to obovoid, tapered at the ends, measuring 5.0-8.7 × 2.8-4.5 µm, av ± SEM = 6.5 ± 0.2 × 3.6 ± 0.1 µm, n = 30.
D3 (DX89) had a growth rate of 28.25 mm per day, and was the fastest-growing isolate collected in this study. The colony white, with profuse, sparse aerial mycelia, in reverse concentric bands caused by hyphal distribution rather than pigmentation at 7 days. Grey, sparse aerial mycelium, irregular medium dark pigment spreading on the bottom of colony at 15 days. The β-conidia were hyaline, unicellular, cylindrical or reniform, curved, and smooth.
D. ueckerae (DX88) had a growth rate of 13.27 mm per day. On the PDA surface with grayish white aerial mycelia, jagged margin, and aerial mycelia forming a suborbicular ring with cottony texture, a pale yellow ring on the reverse side at 7 days. Pale gray, sparse aerial mycelia, with white-pale yellow coloring on the reverse side from the middle to the margin after 15 days of cultivation.
D. lithocarpus (DX87) had a growth rate of 15.87 mm per day. White, woolly, dense aerial mycelia with an uneven margin, forming a circular ring near the center, in reverse radial black pigment in the center at the early phase, and with time, aerial mycelia turned grey, with a lobate margin and in reverse yellowish brown with black patches out of a woolly aerial mycelium ring. Black to brown discoloration in the center at 15 days. In this study, α-conidia produced by these three strains were not obverse. Only round spores were found everywhere (
Figure 6 B-D). The size of D3 (DX89) was 1.7-3.6 µm, av ± SEM = 2.3 ± 0.1 µm, n = 30, that of
D. ueckerae (DX88) 1.8-2.9 µm, av ± SEM = 2.2 ± 0.1 µm, n = 30, and that of
D. lithocarpus (DX87) 1.7-2.6 µm, av ± SEM = 2.1 ± 0.1 µm, n = 30. (
Figure 6)
2.3. Identification and Characterization of Colletotrichum spp.
Among all collected isolates, 45 isolates belonged to
Colletotrichum. Phylogenetic trees (
Figure 7) were constructed using the combined ITS, CAL, TUB2 and GAPDH gene data. The concatenated dataset contained 210 sequences from the genus
Colletotrichum including outgroup
C. xanthorrhoeae (CBS 127831), and 541, 744, 721 and 270 bases had alignment gaps in ITS, CAL, TUB2 and GAPDH, respectively. The isolates in
Colletotrichum collected in the present study belonged to 8 known species, Cf, Cc,
C. aenigma,
C. siamense,
C. henanense,
C. karstii,
C. tropicicola, and
C. gigasporum. The isolates in our study clustered with high posterior probability values ≥ 0.95. Twenty-seven isolates clustered with Cf, 11 isolates clustered with Cc, 2 isolates clustered with
C. aenigma, 1 isolate clustered with
C. siamense, C. henanense, C. karstii, C. tropicicola and
C. gigasporum. Cf and Cc were the largest number of pathogens, accounting for 60% and 24.4% of all
Colletotrichum strains, respectively, and the other 6 species constituted 15.6% of the total. Additionally,
C. tropicicola and
C. gigasporum were first reported in tea plants, which are endophytes in the present study.
In this study, the isolates were cultured on PDA plates to collect of conidia and observe their morphological characteristics (
Figure 8).
C. tropicicola (CX33) had a growth rate of 8.57 mm per day at 25
oC. The colony was flat with complete edges, aerial mycelia that were short and dense, with orange conidial masses near the center, and white with gray pigment spot on the reverse side near the center after 7 days. At 15 days post-inoculation, colonies had an irregularly scalloped margin, the number of orange conidial masses increased, and the reverse side was white with pinkish annulus near the edge. Conidia were hyaline, guttulate, long elliptic with obtuse ends, measuring 11.1-18.5 × 4.8-7.1 µm, av ± SEM = 15.0 ± 0.3 × 5.8 ± 0.1 µm, n = 30.
C. gigasporum (CX34) had flat, smooth edges, with white pigmentation becoming black toward the center, in reverse typically exhibited white-to-black annular pigment after 7 days. The aerial mycelia became sparse, and the central black pigment turned into gray with dark patches scattered randomly around the edge on the reverse side at 15 days. The growth rate was 11.49 mm per day. The conidia (19.9-27.2 × 5.6-8.4 µm, av ± SEM = 23.3 ± 0.3 × 7.1 ± 0.1 µm, n = 30) were hyaline, aseptate, smooth, cylindrical with round ends.
2.4. Pathogenicity Test of Diaporthales Collected from Leaf Surface
To explore the virulence of
Diaporthales strains collected in present study, we used mycelial discs of representative isolates of Dt, D1 and D2 (DX7, DX19, DX22) infecting tender and mature tea leaves to carry out pathogenicity assays. The results were shown in
Figure 9. The maturing status of tea leaves impacted disease development. In tender leaves, early symptoms of disease emerged around the wounded areas at 1 d after inoculation, but mature leaves needed 3 to 4 days. Necrotic lesions were dark and increased in size over time. The spot characteristics and virulence of DX7 and DX19 were similar, while lesions caused by DX22 developed faster and spread along the leaf veins. DX22, which had larger lesions, was more virulent than DX7 and DX19. Conidial suspension was also used to infect tea leaves, but lesions did not emerge (the results were not shown in this study).
2.5. Proportion Analysis of Diaporthales and Colletotrichum
To explore the distribution of all isolates in different classifications, the proportion and quantity of
Diaporthales and
Colletotrichum in this study were analyzed. As shown in
Figure 10A, 32 isolates were collected as endophytes, including 5 species in
Diaporthales and 7 species in
Colletotrichum and were 34.4% and 65.6% of all endophyte, respectively.
D. ueckerae,
D. lithocarpus,
C. siamense,
C. henanense,
C. karstii,
C. tropicicola and
C. gigasporum only existed in the form of endophytes in present study. These results indicated that
Diaporthales accounted for a higher proportion of pathogens than
Colletotrichum, while
Colletotrichum had more varieties.
As shown in
Figure 10B, 101 isolates were identified as
Diaporthales and
Colletotrichum and accounted for 76.2% and 23.8% of pathogens, respectively. Among them, Dt was the most common species, which was a large proportion of all pathogens. 17 strains of Cf were pathogens, which is the highest number of pathogens in
Colletotrichum. The diseased leaves collected in this study can be classified into three types of phenotypic features. There were 35, 39, 27 isolates from P1, P2 and P3 diseased leaves, and the percentages of
Colletotrichum and
Diaporthales were 42.9% and 57.1%, 10.3% and 89.7%, 18.5% and 81.5%, respectively.
2.6. Dual Inoculation Assays of Dt and Colletotrichum
As mentioned above, Dt and
Colletotrichum co-existed in tea leaves. Dual trials
in vitro were carried out to find mutual effect between Dt and
Colletotrichum (
Figure 11). Cf and Cc were used to co-inoculate with Dt, respectively. During 5 days dual growth, it was observed that inhibition percentages of Dt were less than those of
Colletotrichum. As shown in
Figure 11B, Dt and
Colletotrichum maintained a short distance (<2 mm) between them. This performance indicated that Dt and
Colletotrichum had a slight inhibition
in vitro.
To investigate the relationship between them during infection, dual inoculation assays were applied (
Figure 12). As shown in
Figure 12A, the results of single inoculation were consistent with previous studies showing that Cc was more invasive than Cf. The PDA disc of Dt also caused tea leaf disease. Meanwhile, conidial suspensions Cf and Dt did not lead to obvious lesions on tea leaves. The results of dual inoculation were more intriguing (
Figure 12B). The single inoculation and dual inoculation related to virulent Cc had similar results. Dts + Cc and Dtd + Cc gave rise to significantly dark lesions on the tea leaf surface. Nonetheless, combination of Dts + Cf and Dtd + Cf enhanced pathogenicity. Compared to single inoculation, the dual inoculation of Cf and Dt resulted in larger lesions. The results indicated that the dual inoculation of Dt and Cf
in vivo promote the development of tea plant anthracnose.
2.7. Interaction of Dt and Cf on Tea Plant Infection
To explore the impact of fungal biomass on the synergistic effect, we inoculated tea leaves with different concentrations of spore suspensions of Dt and Cf, which were set to 10
5, 10
6 and 10
7 spores/mL (
Figure 13). The single inoculation results indicated that the spore suspension of Dt could not bring about obvious disease spots regardless of how much concentrations of spore suspensions we used. Lower concentrations of Cf (Cf5 and Cf6) caused limited damage to host plants, and the high concentration (Cf7) had the opposite effect, which generated apparent necrosis. As the lesion diameters showed, the lesion size of the F5 group (Dt5Cf5, Dt6Cf5 and Dt7Cf5) was significantly larger than those of Cf5 and Dt5, Dt6, Dt7, as was the F6 group (Dt5Cf6, Dt6Cf6 and Dt7Cf6) compared with those of Cf6 and Dt5, Dt6, Dt7. We also found a significant difference in the F6 group. Compared to single inoculation of Cf7, the F7 group (Dt5Cf7, Dt6Cf7 and Dt7Cf7) caused smaller lesions. Mixing with spore suspensions of low pathogenic Dt may reduce the virulence of highly pathogenic strains. The results showed that dual inoculation of Dt and Cf could promote pathogenicity when they were inoculated independently at lower concentrations. Moreover, the hypovirulent strain may recede the pathogenicity of the high-virulence strain when the pathogenicity of fungi used in dual inoculation differs greatly.
To observe lesions in various inoculations, we found that watery lesions were around the fringe of necrosis when the inoculator is hypovirulent and formed a dispersed distribution on necrosis in the F5 and F6 groups, especially in the F5 group, which did not come into being in strong pathogenic treatment. Furthermore, as a virulent strain, Cc also did not lead to noticeable watery lesions (
Figure S1). It was speculated that watery lesions might play a role in suppressing disease development. To explore the composition and function watery lesions may be a meaningful research in the future.
3. Discussion
3.1. Phenotype and Isolated Main Fungi of Diseased Tea Leaves
As a main tea disease, anthracnose affects the yield and quality of tea [
1]. The main causes of tea anthracnose in China were previously unclear, primarily because of the controversy of
Diaporthales and
Colletotrichum. According to previous studies,
Colletotrichum is considered the dominant species causing anthracnose in tea plants in China, while Dt (a species of
Diaporthales) is the major fungal leading to tea anthracnose in Japan [5, 18, 20]. In the first year, we collected tea foliage with anthracnose and isolated both
Diaporthales and
Colletotrichum. In order to verify the results, we repeated the experiment with new diseased tea leaves with anthracnose the next year, nevertheless, both aforementioned fungi also could be detected. Furthermore, 88
Diaporthales and 45
Colletotrichum isolates were collected from diseased tea leaves of anthracnose. This result indicated that both
Diaporthales and
Colletotrichum coexisted in diseased tea leaves in China. Among them, 32 isolates were endophytes, 77 and 24 isolates in
Diaporthales and
Colletotrichum were isolated from tea leaves surface, respectively. Therefore,
Diaporthales widely exist in diseased tea plants as pathogens. This is a new viewpoint that can guide the research of anti-anthracnose of tea plant with more accurate pathogen recognitions. Moreover, combined with the taxonomic results and isolation rate, we can easily find that Dt and Cf are dominant species in
Diaporthales and
Colletotrichum.
Phenotypic identification of diseased leaves in the field is the main means to determine the specific disease of tea plants by far. Whereas, two typical tea diseases as anthracnose and tea leaf blight are easily confused, due to the complexity of environmental factors and the similarity of disease spots. According to the previous studies, when the tea plants get anthracnose or tea leaf blight, the tea leaves both would have subround or irregular scabs with scattered little black sporophores. The size and density of acervuli as well as brown and white thin ring spots on the scab were considered mainly difference between the two tea plant diseases. Furthermore, watery lesions were used to identified anthracnose in the field. In this study, we collected the pahtogens among three different typical anthracnose symptoms, which all have subround or irregular scabs, scattered little black sporophores, watery lesions and no thin ring spots. All three main fungi, Cc, Cf and Dt, can be found in topical anthracnose leaves collected in this study. Interestingly, all pathogenic isolates collected from A2 were Cf. This result could be a good example to investigate the relationship between specific pathogens and micro-characteristics (such as acervuli form) of plant disease. In the meantime, we found that watery lesions always occurred in the weakly pathogenic infection process rather than the highly pathogenic form. Therefore, we considered that watery lesions could be a phenotype of defense mechanisms of tea plants to prevent pathogens from entering tissues and cells.
3.2. Characterization and Diversity of Diaporthales from tea plant
For a long time, the taxonomy of
Diaporthales species was unclear. Species recognition principles in
Diaporthales have been dependent on culture characteristics, ascospore shape and perithecium position [
24]. Currently, accurate DNA data coupled with conidial characteristics are used in scientific studies to identify and classify
Diaporthales. LSU nrDNA, 28S nrDNA, EF1 and RPB2 have been used to investigate the phylogenetic relationships within
Diaporthales [6, 14, 25]. 31 families are regarded as belonging to
Diaporthales via molecular data so far [
11]. In our study,
Diaporthales species were resolved through ITS, LSU, EF1 and RPB2 gene sequence analysis with high bootstrap support. Six different species in
Diaporthales were collected in this study, including 3 indistinguishable species and 3 known species. Twenty isolates were unascertainable, which fell into 3 clades (D1, D2 and D3) of
Diaporthales with 91% bootstrap support. Although there was minor morphological information of DX87 and DX88, the bayesian posterior probability values of both DX87 and DX88 were 1, which supported the identification results of the species. Due to stability within some species, the characteristics of conidia are usually used for identification. In previous reports,
Diaporthales species produced α-, β- and γ- conidia [13, 26]. In the present study, most of α conidial cells of
Diaporthales species can be observed, which are fusiform or obovoid, and tapered at the ends. The length of α conidium ranges from 4.8 to 6.4 µm in
Diaporthales species, which was smaller than that in
Colletotrichum.
Taxonomy of Dt only depends on morphological characteristics previously. So this fungus was named as
G. theae-sinensis and
C. theae-sinensis [
3], which was identified as one of
Diaporthales species until using molecular date [
14]. According to BI analyses in our study, 66 isolates clustered with MAFF 238240 to 238244 collected from Moriwaki et al were recognized as Dt. In addition, the length range of Dt conidia in our study was 4.8-6.4 × 2.4-2.8 µm, which was the same as Moriwaki’s result [
14]. Although the correct position of Dt in
Diaporthales has not been determined due to lack of teleomorph, we can affirm the main cause led anthracnose in Japan also accounted for the largest number of all
Diaporthales isolates on tea disease leaves in China.
3.3. Interaction of Dt and Colletotrichum in vitro and in vivo
The results from
in vitro dual assays between Dt and
Colletotrichum revealed that both of them inhibited each other growth
in vitro. Skidmore and Dickinson classified colony interactions among fungi into five categories, which were mutually intermingling growth, two types of intermingling growth, slight inhibition and mutual inhibition at a distance. During the dual trials
in vitro, Dt and
Colletotrichum approached each other until almost in contact, and no intermingling growth. It was indicated mode of interacting colony growth of Dt and
Colletotrichum (Cf and Cc) was slight inhibition. Interestingly, an aggravation of the condition had been observed in dual inoculation of Dt and Cf on tea leaves, but not in Dt and Cc. According to previous studies and pathogenicity tests in this study, we found that Cc is more virulent than Dt and Cf, and low concentrations of spore suspensions of Dt and Cf do not cause disease spot occurrence on tea leaves [18, 21]. Co-inoculation with different concentrations of spore suspensions were performed to explore the effect of Cc, CF and Dt during the infection. At the low concentration (Cf can not cause tea plant disease in this concentration range), the dual inoculation of Dt and Cf caused lesions in tea leaves and significantly enhanced the infection capacity compared with single inoculation. We hypothesized that Dt and Cf, the most common species, may adopt a certain way to cause tea plant disease. With the increasing of concentrations of spore suspensions, the virulence of Cf enhanced. Meanwhile, the pathogenicity gain of coaction of Dt and Cf disappeared (
Figure 13). Therefore, we considered the main cause of anthracnose might be the concerted action of a variety of fungi.
The results of this study are novel and inspiring because we found that the dominant species of tea anthracnose consisted of both Diaporthales and Colletotrichum in China. Based on characterization and phylogenetic analysis of those two categories, 3 known species and 3 indistinguishable species were collected in Diaporthales, and 8 known species were collected in Colletotrichum, among which C. tropicicola and C. gigasporum were first reported in tea plant. According to the pathogenicity test, mycelial discs of Dt cause tea anthracnose, while coaction of Dt and Cf enhance virulence of tea plants during the infection process. The main cause of anthracnose might be the concerted action of a variety of fungi. This study offers a novel insight that will further tea anthracnose research.
4. Materials and Methods
4.1. Collection and Isolation
Tea leaves were collected from
Camellia sinensis cv.
Longjing43 (LJ43) in three different tea gardens of Zhejiang Province, China. Diseased samples were identified and collected from leaves with visible anthracnose infected symptoms, in terms of tea disease profile [
27]. The isolates separated from leaves were obtained by a single spore isolation technique described by Cai et al. [
28]. In addition, the endophytic fungi were isolated according to a protocol from Kjer et al [
29]. Briefly, the endophytic fungi were collected after washing diseased leaves by tap water, alcohol (70%) for 1 min, sodium hypochlorite (2.5%) for 1 min, and then washed in sterile distilled water.
4.2. Morphological Characterization
The colony and conidial characteristics were determined methods described by Cai et al. [
28]. Mycelial discs (5 mm diameter) were taken from the margin of 5-day-old cultures and incubated on PDA plates in the dark at 25
oC overnight. Each isolate was measured at least three independent experiments. The colony diameter was measured from 1 to 4 days after inoculation used for calculating the growth rate (mm/d). The colony characteristics were also recorded.
4.3. Molecular Characterization
Total genomic DNA, which was used as the template for PCR amplification, was extracted using an Ezup Column Fungi Genomic DNA Purification Kit [Sangon Biotech (Shanghai) Company Limited, Shanghai, China] and stored at -20
oC. Four partial loci were used for
Colletotrichum identification, including ribosomal internal transcribed spacer (ITS), glyceraldehyde 3-phosphate dehydrogenase (GAPDH), beta-tubulin (TUB2) and calmodulin (CAL) genes. Other partial loci, such as ITS, the partial 28S nrDNA (LSU), DNA-directed RNA polymerase II second largest subunit (RPB2), and translation elongation factor 1-alpha (EF1) were used to identify
Diaporthales. The primers used in this study are listed in
Table S1, while the polymerase chain reaction (PCR) was performed as follows: 4 min at 94
oC; followed by 35 cycles of 30 s at 94
oC; 50 s at 57
oC (LSU) or 54
oC (EF1) or 55
oC (RPB2); 30 s at 72
oC, and 10 min at 72
oC. The PCR conditions for ITS, GAPDH, TUB2 and CAL were as described by Lu et al. [
21]. PCR purification and DNA sequencing were performed by Shanghai Huagene Biotech Company Limited, Shanghai, China.
4.4. Phylogenetic Analysis
The accession numbers of the sequences were obtained from NCBI GenBank based on BLAST searches and published literature and are listed in
Tables S2 and S3. Sequences from forward and reverse primers were edited with SeqMan and DNAStar. We used Bayesian inference (BI) to construct the phylogenies according to multilocus sequence analysis. MrBayes v. 3.2. MrModel test v. 2.3 was used to select the bestfit models of nucleotide substitution, then assembling and modulating the dataset by MAFFT v.7 and MEGA v. 6.0, respectively. All gaps were regarded as missing data. Markov chain Monte Carlo (MCMC) sampling was used to reconstruct the phylogenies in MrBayes v. 3.2. Analyses of 6 MCMC chains based on the full dataset were run for 2 × 10
7 generations and sampled every 100 generations [21, 30].
4.5. Pathogenicity Tests of Discula theae-sinensis
First, the healthy, nonwounded tender and mature tea leaves were washed with tap water and then sterilized with 1% sodium hypochlorite for 2 min, flushed with sterilized water 3 times, and air dried. Afterward, sterile needles were used to puncture the leaves to make wounded spots. Subsequently, 5-mm mycelial discs from a 5-day-old culture were placed over every wound of tea leaves. The inoculated leaves were cultured in an incubator at 25 oC with a 12/12 h (day/night) photoperiod. The conditions of inoculated leaves were recorded at 1-2 and 4-5 days post-inoculation in tender and mature tea leaves, respectively. Finally, Koch’s postulates were employed to investigate each strain. Test of each isolate was performed in three biological replicates.
4.6. Dual Inoculation Assays of Dt and Colletotrichum
The plate confrontation culture method was used to assess the mutual effect between Dt and
Colletotrichum spp.
in vitro. The PDA plates were cultured in an incubator at 25
oC for 5 days in the dark. And then, observed the mutual effect between strains. The formula of inhibition ratio of growth of fungi were calculated described by López-González et al. was followed with minor revisions [
31].
Where R1 indicates the radial growth of the fungi colony in control plates and R2 indicates the radial growth of the fungi colony (in the direction of the other fungus).
Dual assays in vivo were used to explore the relationship between Dt and Colletotrichum spp. during the procession of infection. The method of leaf preparation and inoculation condition were same as pathogenicity test. The inoculation experiments were grouped into 9 treatments and labels as follows: ① Control, distilled water treatment; ② Dts, single inoculation of spore suspension of Dt; ③ Dtd, single inoculation of mycelial discs of Dt; ④ Cc, single inoculation of spore suspension of Cc; ⑤ Cf, single inoculation of spore suspension of Cf. ⑥ Dts + Cc, dual inoculation with a spore suspension of Dt and Cc; ⑦ Dtd + Cc, dual inoculation with mycelial discs of Dt and a spore suspension of Cc; ⑧ Dts + Cf, dual inoculation with spore suspension Dt and Cf; ⑨ Dtd + Cf, dual inoculation with mycelial discs of Dt and spore suspension of Cf. The concentration of spore suspension was 106 spores/mL in these experiments.
4.7. Impact of Spore Suspension Concentration on Combined Dt and Cf Infection Capacity
To explore the interaction of Dt and Cf at various concentrations in a spore suspension, inocula were prepared by mixing spore suspensions of Dt and Cf in equal amounts. The concentration of the spore suspension was 10
5 spores/mL, 10
6 spores/mL and 10
7 spores/mL. Six single inoculations and 9 combinations were obtained. The labels and corresponding treatment conditions are shown in
Table 1.
4.8. Statistical Analysis and Microscopic Observation
SPSS 19 software was used to analysis of variance (ANOVA) of the experimental data. The mean values were compared by the least significant difference (LSD) method, and differences were considered significant at p < 0.05. All data are represented as the average ± standard error.
An OLYMPUS stereo microscope was used to observe acervuli on diseased tea leaves from the field. A Nikon 80i microscope equipped with a differential interference contrast (DIC) objective was used to visualize spores on diseased tea leaves. Lesion observation after dual inoculation were performed using field-depth microscope (KEYENCE). Conidial characteristics were recorded by ZEISS Axio Vert. A1
5. Conclusions
We explored the dominant species of anthracnose of tea plant in China and investigated the diversity of Diaporthales and Colletotrichum associated with Ca. sinensis. In Diaporthales, 3 known species and 3 indistinguishable species were collected. Dt was the most common species in tea leaves and caused tea plant disease. We identified 8 known species in Colletotrichum. C. tropicicola and C. gigasporum were first reported in tea plant. In addition, co-inoculating Discula theae-sinensis and C. fructicola was superior to single inoculation at low concentration.
Supplementary Materials
The following supporting information can be downloaded at the website of this paper posted on
Preprints.org. Figure S1: Details of lesions of inoculation with Cc and dual inoculations of Cc and Dt; Table S1: Primers used in this study; Table S2: Isolates
Diaporthales spp. studied and GenBank accession numbers of the generated sequences; Table S3: Isolates
Colletotrichum spp. studied and GenBank accession numbers of the generated sequences.
Author Contributions
Conceptualization, Q.-H.L.; Methodology, Q.-S.L. and Q.-H.L.; Validation, D.L., R.N., Y.J.; Investigation, J.-Y.Z. D.L., R.N. W.-Y.L.; Data Curation; Q.-H.L. Writing—Original Draft Preparation, Q.-H.L. Q.-S.L.; Writing—Review & Editing, Q.-S.L.; Supervision, J.-Y.Z. Administration, J.-Y.Z.; Funding Acquisition, Q.-H.L., Q.-S.L. W.-Y.L. and J.-Y.Z. All authors have read and agreed to the published version of the manuscript.
Funding
This work was funded by the Open Fund of State Key Laboratory of Tea Plant Biology and Utilization (SKLTOF20200124), the study was funded by Zhejiang Science and Technology Major Program on Agricultural New Variety Breeding-Tea Plant (2021C02067-7), the National Natural Science Foundation of China (Project No.32202545, No.32102438, No.32202536 ), the Discipline Start-up Fund of Zhejiang Academy of Agricultural Sciences (10405080121CC2201G), the Talent Start-up Fund of Zhejiang Academy of Agricultural Sciences (10405010120CF0401G/001), the Innovation and utilization of Characterized Germplasm of Tea Plant in Huzhou (2022SY010).
Institutional Review Board Statement
Not applicable.
Informed Consent Statement
Not applicable.
Data Availability Statement
Data are available on request from the corresponding author.
Acknowledgments
We express our gratitude to Professor Xin-Chao Wang and his group from Tea Resources and Improvement Research Center, Tea Research Institute of Chinese Academy of Agricultural Sciences, Hangzhou, China for their guidance and sample sharing.
Conflicts of Interest
The authors declare no competing financial interest.
References
- Guo, M.; Pan, Y.; Dai, Y.; Gao, Z. First report of brown blight disease caused by Colletotrichum gloeosporioides on Camellia sinensis in Anhui Province, China. Plant Dis. 2014, 98, 284–284. [Google Scholar] [CrossRef]
- Ling, G.H.; Chen, X.Y. Occurrence and control countermeasures of tea tree anthracnose in Xinchang County. China Tea (In Chinese). 2015, 268, 19-19. [Google Scholar] [CrossRef]
- Weir, B.S.; Johnston, P.R.; Damm, U. The Colletotrichum gloeosporioides species complex. Stud Mycol. 2012, 73, 115–180. [Google Scholar] [CrossRef] [PubMed]
- Yamamoto, W. A. revision of the genus and species names of anthracnose fungi in Japan. Plant Prot. 1960, 14, 49–52. [Google Scholar]
- Moriwaki, J.; Sato, T. A new combination for the causal agent of tea anthracnose: Discula theae-sinensis (I. Miyake) Moriwaki & Toy. Sato, comb. nov. J. Gen. Plant Pathol. 2009, 75, 359–361. [Google Scholar] [CrossRef]
- Castlebury, L.A.; Rossman, A.Y.; Jaklitsch, W.J.; Vasilyeva, L.N. A preliminary overview of the Diaporthales based on large subunit nuclear ribosomal DNA sequences. Mycol. 2002, 94, 1017–1031. [Google Scholar] [CrossRef]
- Sogonov, M.V.; Castlebury, L.A.; Rossman, A.Y.; White, J.F. The type species of Apiognomonia, A. veneta, with its Discula anamorph is distinct from A. Errabunda. Mycol. Res. 2007, 111, 693–709. [Google Scholar] [CrossRef]
- Senanayake, I.C.; Crous, P.W.; Groenewald, J.Z.; Maharachchikumbura, S.S.N.; Jeewon, R.; Phillips, A.J.L.; Bhat, J.D.; Perera, R.H.; Li, Q.R.; Li, W.J.; Tangthirasunun, N.; Norphanphoun, C.; Karunarathna, S.C.; Camporesi, E.; Manawasighe, I.S.; Al-Sadi, A.M.; Hyde, K.D. Families of Diaporthales based on morphological and phylogenetic evidence. Studies Mycologia, 2017, 86, 217–296. [Google Scholar] [CrossRef]
- Yang, Q.; Fan, X.L.; Du, Z.; Tian, C.M. Diaporthosporellaceae, a novel family of Diaporthales (Sordariomycetes, Ascomycota). Mycoscience. 2018, 59, 229–235. [Google Scholar] [CrossRef]
- Jiang, N.; Fan, X.; Tian, C.; Crous, P.W. Reevaluating Cryphonectriaceae and allied families in Diaporthales. Mycologia. 2020, 112, 267–292. [Google Scholar] [CrossRef]
- Udayanga, D.; Miriyagalla, S.D.; Manamgoda, D.S.; Lewers, K.S.; Gardiennet, A.; Castlebury, L.A. Molecular reassessment of diaporthalean fungi associated with strawberry, including the leaf blight fungus, Paraphomopsis obscurans gen. et comb. nov. (Melanconiellaceae). IMA Fungus. 2021, 12, 1–21. [Google Scholar] [CrossRef]
- Xie, H.; Feng, X.; Wang, M.; Wang, Y.; Kumar Awasthi, M.; Xu, P. Implications of endophytic microbiota in Camellia sinensis: a review on current understanding and future insights. Bioengineered. 2020, 11, 1001–1015. [Google Scholar] [CrossRef] [PubMed]
- Gao, Y.; Liu, F.; Cai, L. Unravelling Diaporthe species associated with Camellia. Syst. Biodivers. 2016, 14, 102–117. [Google Scholar] [CrossRef]
- Yamada, K.; Sonoda, R. A fluorescence microscopic study of the infection process of Discula theae-sinensis in tea. Jpn. Agr. Res. Q: 2014, 48, 399–402. [Google Scholar] [CrossRef]
- Kim, K.W. Plant trichomes as microbial habitats and infection sites. Eur. J. Plant Pathol. 2019, 154, 157–169. [Google Scholar] [CrossRef]
- Latunde-Dada, A.O. Colletotrichum: tales of forcible entry, stealth, transient confinement and breakout. Mol Plant Pathol. 2001, 12, 187–198. [Google Scholar] [CrossRef]
- Fang, W.; Yang, L; Zhu, X.; Zeng, L.; Li, X. Seasonal and habitat dependent variations in culturable endophytes of Camellia sinensis. Journal of Plant Pathology & Microbiology 2013, 4, 1000169. [Google Scholar] [CrossRef]
- Wang, Y.C.; Hao, X.Y.; Wang, L.; Xiao, B.; Wang, X.C.; Yang, Y.J. Diverse Colletotrichum species cause anthracnose of tea plants (Camellia sinensis (L.) O. Kuntze) in China. Sci. Rep. 2016, 6, 1–13. [Google Scholar] [CrossRef]
- Zhang, L.; Li, X.H.; Zhou, Y.Y.; Tan, G.J.; Zhang, L.X. Identification and characterization of Colletotrichum species associated with Camellia sinensis anthracnose in Anhui province, China. Plant Dis., 2021, 105, 2649–2657. [Google Scholar] [CrossRef]
- Liu, F.; Weir, B.S.; Damm, U.; Crous, P.W.; Wang, Y.; Liu, B.; Wang, M.; Zhang, M.; Cai, L. Unravelling Colletotrichum species associated with Camellia: employing ApMat and GS loci to resolve species in the C. gloeosporioides complex. Persoonia. 2015, 35, 63–86. [Google Scholar] [CrossRef]
- Lu, Q.; Wang, Y.; Li, N.; Ni, D.; Yang, Y.; Wang, X. Differences in the characteristics and pathogenicity of Colletotrichum camelliae and C. fructicola Isolated from the tea plant (Camellia sinensis (L.) O. Kuntze). Front. Microbiol. 2018, 9, 3060. [Google Scholar] [CrossRef]
- Li, X.; Wang, Z.K.; Tan, W.Z.; Zhang, K.C.; Li, P.; Wang, Z.W.; Yin, L.L.; Tan, S.X. Effects of wuyiencin on growth and sporulation of Colletotrichum camelliae causing tea leaf blight. J. Southwest China Norm. Univ. (Natural Science Edition) (In Chinese). 2008, 33, 42–47. [Google Scholar] [CrossRef]
- Chen, Y.; Qiao, W.L.; Zeng, L.; Shen, D.; Liu, Z.L.; Wang, X.S.; Tong, H. Characterization, pathogenicity, and phylogenetic analyses of Colletotrichum species associated with brown blight disease on Camellia sinensis in China. Plant Dis. 2017, 106, 1022–1028. [Google Scholar] [CrossRef]
- Barr, M.E. The Diaporthales in North America with emphasis on Gnomonia and its segregates. Mycologia memoir. 1978, 7, 1–232. [Google Scholar] [CrossRef]
- Senanayake, I.C.; Jeewon, R.; Chomnunti, P.; Wanasinghe, D.N.; Norphanphoun, C.; Karunarathna, A.; Pem, D.; Perera, R.H.; Camporesi, E.; McKenzie, E.H.C.; Hyde, K.D.; Karunarathna, S.C. Taxonomic circumscription of Diaporthales based on multigene phylogeny and morphology. Fungal Divers. 2018, 93, 241–443. [Google Scholar] [CrossRef]
- Crous, P.W.; Summerell, B.A.; Shivas, R.G.; Burgess, T.I.; Decock, C.A.; Dreyer, L.L.; et al. Fungal Planet description sheets:107-127. Persoonia. 2012, 28, 138–182. [Google Scholar] [CrossRef]
- Tang, M.J.; Xiao, Q. Colored Pictorial Handbook of Tea Plant Pests and Natural Enemies. Beijing. China Agricultural University Press, Beijing, China. 2019, 4-5.
- Cai, L.; Hyde, K.D.; Taylor, P.; Weir, B.S.; Waller, J.M.; Abang, M.M.; Zhang, J.Z.; Yang, Y.L.; Phoulivong, S.; Liu, Z.Y.; Prihastuti, H.; Shivas, R.G.; McKenzie, E.H.C.; Johnston, P.R. A polyphasic approach for studying Colletotrichum. Fungal Divers. 2009, 39, 183–204. [Google Scholar]
- Kjer, J.; Debbab, A.; Aly, A.H.; Proksch, P. Methods for isolation of marine-derived endophytic fungi and their bioactive secondary products. Nat. protoc. 2010, 5, 479–490. [Google Scholar] [CrossRef]
- Yan, J.Y.; Jayawardena, M.; Goonasekara, I.D.; Yong, W.; Wei, Z.; Mei, L.; Huang, J.B.; Wang, Z.Y.; Shang, J.; Peng, Y.L.; Bahkali, A.; Hyde, K.D.; Li, X.H. Diverse species of Colletotrichum associated with grapevine anthracnose in China. Fungal Divers. 2015, 71, 233–246. [Google Scholar] [CrossRef]
- López-González, R.C.; Gómez-Cornelio, S.; Rosa-García, D.; Garrido, E.; Oropeza-Mariano, O.; Heil, M.; Partida-Martínez, L. The age oflima bean leaves influences the richness and diversity of the endophytic fungal community, but not the antagonistic effect of endophytes against Colletotrichum lindemuthianum. Fungal Ecol. 2017, 26, 1–10. [Google Scholar] [CrossRef]
Figure 1.
Phenotypic characterization of diseased tea leaves. (A) Morphology of tea leaves. Black triangles indicate watery lesions. (B) Shape of acervuli on tea leaves. (C) Spores isolated from lesions. Red arrows indicate spores.
Figure 1.
Phenotypic characterization of diseased tea leaves. (A) Morphology of tea leaves. Black triangles indicate watery lesions. (B) Shape of acervuli on tea leaves. (C) Spores isolated from lesions. Red arrows indicate spores.
Figure 2.
Phylogenetic tree generated by Bayesian analysis based on a combined 4-gene dataset (ITS, LSU, EF1 and RPB2). Bayesian posterior probabilities above 0.95 are shown at each node. Lopadostoma polynesium LAG was used as the outgroup. The scale bar indicates 0.05 expected changes per site. The branches crossed by diagonal lines are shortened by 75%. The ex-type strains are emphasized in bold. Red squares indicate strains isolated in 2019; blue squares indicate strains isolated in 2020; red circles indicate pathogens; blue circles indicate endophytes; white triangles indicate strains isolated from P1; yellow triangles indicate strains isolated from P2, black triangles indicate strains isolated from P3.
Figure 2.
Phylogenetic tree generated by Bayesian analysis based on a combined 4-gene dataset (ITS, LSU, EF1 and RPB2). Bayesian posterior probabilities above 0.95 are shown at each node. Lopadostoma polynesium LAG was used as the outgroup. The scale bar indicates 0.05 expected changes per site. The branches crossed by diagonal lines are shortened by 75%. The ex-type strains are emphasized in bold. Red squares indicate strains isolated in 2019; blue squares indicate strains isolated in 2020; red circles indicate pathogens; blue circles indicate endophytes; white triangles indicate strains isolated from P1; yellow triangles indicate strains isolated from P2, black triangles indicate strains isolated from P3.
Figure 3.
Growth rates of Diaporthales spp. strains. Different letters indicate significant differences according to one-way ANOVA (p value < 0.05).
Figure 3.
Growth rates of Diaporthales spp. strains. Different letters indicate significant differences according to one-way ANOVA (p value < 0.05).
Figure 4.
Morphological characteristics of Dt. Scale bar = 20 µm.
Figure 4.
Morphological characteristics of Dt. Scale bar = 20 µm.
Figure 5.
Morphological characteristics of indistinguishable Diaporthales spp. (D1, D2). Scale bar = 20 µm.
Figure 5.
Morphological characteristics of indistinguishable Diaporthales spp. (D1, D2). Scale bar = 20 µm.
Figure 6.
Morphological characteristics of D3, D. ueckerae and D. lithocarpus (A) Photographs of colonies. (B-D) Zoospores of D3, D. ueckerae and D. lithocarpus. (E) β-conidia of D3. (F-G) Conidiogenous cells of D3 and D. lithocarpus. Scale bar = 20 µm.
Figure 6.
Morphological characteristics of D3, D. ueckerae and D. lithocarpus (A) Photographs of colonies. (B-D) Zoospores of D3, D. ueckerae and D. lithocarpus. (E) β-conidia of D3. (F-G) Conidiogenous cells of D3 and D. lithocarpus. Scale bar = 20 µm.
Figure 7.
Phylogenetic tree generated by Bayesian analysis based on a combined 4-gene dataset (ITS, CAL, TUB2 and GAPDH). Bayesian posterior probabilities above 0.95 are shown at each node. C. xanthorrhoeae CBS 127831 was used as the outgroup. The scale bar indicates 0.05 expected changes per site. The branches crossed by diagonal lines are shortened by 75%. The ex-type strains are emphasized in bold. red squares indicate strains isolated in 2019; blue squares indicate strains isolated in 2020; red circles indicate pathogens; blue circles indicate endophytes; white triangles indicate strains isolated from P1; yellow triangles indicate strains isolated from P2, black triangles indicate strains isolated from P3.
Figure 7.
Phylogenetic tree generated by Bayesian analysis based on a combined 4-gene dataset (ITS, CAL, TUB2 and GAPDH). Bayesian posterior probabilities above 0.95 are shown at each node. C. xanthorrhoeae CBS 127831 was used as the outgroup. The scale bar indicates 0.05 expected changes per site. The branches crossed by diagonal lines are shortened by 75%. The ex-type strains are emphasized in bold. red squares indicate strains isolated in 2019; blue squares indicate strains isolated in 2020; red circles indicate pathogens; blue circles indicate endophytes; white triangles indicate strains isolated from P1; yellow triangles indicate strains isolated from P2, black triangles indicate strains isolated from P3.
Figure 8.
Morphological characteristics of C. tropicicola and C. gigasporum. (A) Morphological structures of C. tropicicola (CX33) and C. gigasporum (CX34), Scale bar = 20 µm. (B) Histogram of growth rate.
Figure 8.
Morphological characteristics of C. tropicicola and C. gigasporum. (A) Morphological structures of C. tropicicola (CX33) and C. gigasporum (CX34), Scale bar = 20 µm. (B) Histogram of growth rate.
Figure 9.
Pathogenicity tests of Dt (DX7), D1 (DX19) and D2 (DX22) on tea plant leaves after inoculation.
Figure 9.
Pathogenicity tests of Dt (DX7), D1 (DX19) and D2 (DX22) on tea plant leaves after inoculation.
Figure 10.
Percentage bar graphs of Colletotrichum and Diaporthales in different classifications. (A) The proportions of Colletotrichum and Diaporthales in endophytes and pathogens. (B) The proportion of Colletotrichum and Diaporthales in three types of phenotype.
Figure 10.
Percentage bar graphs of Colletotrichum and Diaporthales in different classifications. (A) The proportions of Colletotrichum and Diaporthales in endophytes and pathogens. (B) The proportion of Colletotrichum and Diaporthales in three types of phenotype.
Figure 11.
Dual inoculation in vitro at 5 days. (A) Growth inhibition of Dt and Colletotrichum (B) Plate confrontation culture between Dt (left) and Colletotrichum (right).
Figure 11.
Dual inoculation in vitro at 5 days. (A) Growth inhibition of Dt and Colletotrichum (B) Plate confrontation culture between Dt (left) and Colletotrichum (right).
Figure 12.
Dual inoculation in vivo. (A) Results of single inoculation. (B) Results of dual inoculation. Cc: single inoculation of spore suspension of Cc; Cf: single inoculation of spore suspension of Cf; Dts: single inoculation of spore suspension of Dt; Dtd: single inoculation of mycelial discs of Dt. Dts + Cc: used spore suspension of Dt and Cc for dual inoculation; Dtd + Cc: used mycelial discs Dt and spore suspension of Cc for dual inoculation; Dts + Cf: used spore suspension of Dt and Cf for dual inoculation; Dtd + Cf: used spore suspension of Cf and mycelial discs Dt for dual inoculation.
Figure 12.
Dual inoculation in vivo. (A) Results of single inoculation. (B) Results of dual inoculation. Cc: single inoculation of spore suspension of Cc; Cf: single inoculation of spore suspension of Cf; Dts: single inoculation of spore suspension of Dt; Dtd: single inoculation of mycelial discs of Dt. Dts + Cc: used spore suspension of Dt and Cc for dual inoculation; Dtd + Cc: used mycelial discs Dt and spore suspension of Cc for dual inoculation; Dts + Cf: used spore suspension of Dt and Cf for dual inoculation; Dtd + Cf: used spore suspension of Cf and mycelial discs Dt for dual inoculation.
Figure 13.
The interaction of Cf and Dt on tea plant infection. (A) Bar chart of the diameter of lesions of different inoculation treatments. Asterisks indicate significant difference between single inoculation of Dt, Cf5, Cf6 and Dual inoculation according to one-way ANOVA (p value < 0.05). letters represent differences between Cf7 and dual inoculations of F7 group. The Error bars indicate standard error (SE). (B) Images of lesions after different inoculation treatments. Black triangles indicate watery lesions, scale bar = 100 µm. The meaning of labels is shown in
Table 1.
Figure 13.
The interaction of Cf and Dt on tea plant infection. (A) Bar chart of the diameter of lesions of different inoculation treatments. Asterisks indicate significant difference between single inoculation of Dt, Cf5, Cf6 and Dual inoculation according to one-way ANOVA (p value < 0.05). letters represent differences between Cf7 and dual inoculations of F7 group. The Error bars indicate standard error (SE). (B) Images of lesions after different inoculation treatments. Black triangles indicate watery lesions, scale bar = 100 µm. The meaning of labels is shown in
Table 1.
Table 1.
Labels and corresponding treatment conditions in this sector.
Table 1.
Labels and corresponding treatment conditions in this sector.
| |
Labels |
Treatment conditions |
| Single inoculation |
|
Dt5 |
105 spores/mL spore suspension of Dt |
| |
Dt6 |
106 spores/mL spore suspension of Dt |
| |
Dt7 |
107 spores/mL spore suspension of Dt |
| |
Cf5 |
105 spores/mL spore suspension of Cf |
| |
Cf6 |
106 spores/mL spore suspension of Cf |
| |
Cf7 |
107 spores/mL spore suspension of Cf |
| Dual inoculation |
F5 group |
Dt5Cf5 |
105 spores/mL Dt and 105 spores/mL Cf |
| Dt6Cf5 |
106 spores/mL Dt and 105 spores/mL Cf |
| Dt7Cf5 |
107 spores/mL Dt and 105 spores/mL Cf |
| F6 group |
Dt5Cf6 |
105 spores/mL Dt and 106 spores/mL Cf |
| Dt6Cf6 |
106 spores/mL Dt and 106 spores/mL Cf |
| Dt7Cf6 |
107 spores/mL Dt and 106 spores/mL Cf |
| F7 group |
Dt5Cf7 |
105 spores/mL Dt and 107 spores/mL Cf |
| Dt6Cf7 |
106 spores/mL Dt and 107 spores/mL Cf |
| Dt7Cf7 |
107 spores/mL Dt and 107 spores/mL Cf |
|
Disclaimer/Publisher’s Note: The statements, opinions and data contained in all publications are solely those of the individual author(s) and contributor(s) and not of MDPI and/or the editor(s). MDPI and/or the editor(s) disclaim responsibility for any injury to people or property resulting from any ideas, methods, instructions or products referred to in the content. |
© 2023 by the authors. Licensee MDPI, Basel, Switzerland. This article is an open access article distributed under the terms and conditions of the Creative Commons Attribution (CC BY) license (http://creativecommons.org/licenses/by/4.0/).